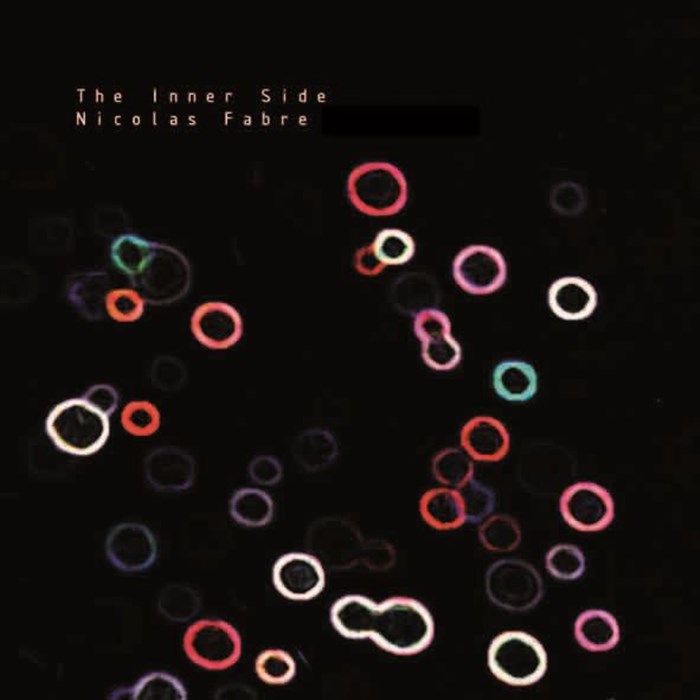

Il joue actuellement ses compositions en trio avec le contrebassiste Richard Apté et le batteur Max Hartock...
Nicolas Fabre s'est produit dans plusieurs festivals dans les pays de Loire, également dans des salles parisiennes en trio avec Philippe Combelle et Richard Apté notamment, dans le groupe de jazz électrique Pagaille (avec le batteur Sonny Troupé), ainsi que dans le groupe expérimental Mental Routage. Il joue également pour le théâtre, dans le spectacle Struggle avec Michel Aymard et dans le spectacle l.a.d.i.e.s.
Il vient de sortir un album de ses compositions en piano soso "The Inner Side". Dans le prolongement de cet album, il joue actuellement ses compositions en trio avec le contrebassiste Richard Apté et le batteur Max Hartock.
Lire la suite
Pour tout public
Langue : français
Il vient de sortir un album de ses compositions en piano soso "The Inner Side". Dans le prolongement de cet album, il joue actuellement ses compositions en trio avec le contrebassiste Richard Apté et le batteur Max Hartock.
Nicolas Fabre Trio, les avis spectateurs
Connecte-toi pour donner ton avis !
Il n'y a pas encore d’avis 😭
Nicolas Fabre Trio, les photos du spectacle
Le lieu
Tu pourrais aimer aussi !
Nicolas Fabre Trio, toutes les séances

Aucune date prévue pour le moment
À propos de Nicolas Fabre Trio
L’événement Nicolas Fabre Trio de type Concerts, organisé ici :
L'entrepôt - 14ème -
Paris, n'est plus disponible à la vente.
Toujours à la recherche de la sortie idéale ? Voici quelques pistes :
Voir plus
Toujours à la recherche de la sortie idéale ? Voici quelques pistes :